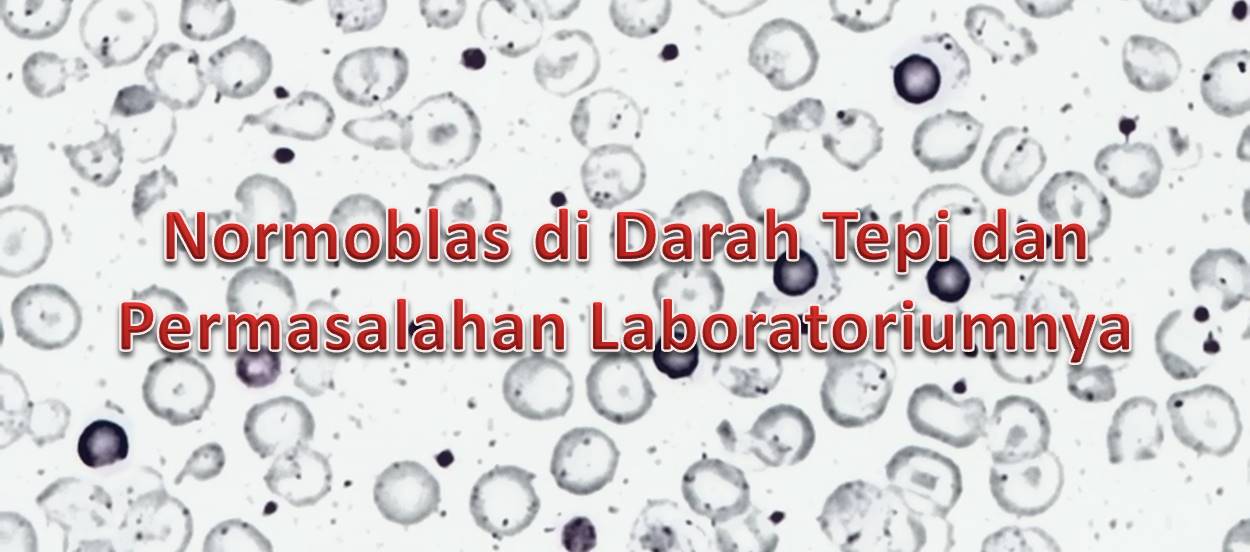
Normoblas di Darah Tepi dan Permasalahan Laboratoriumnya

Pemeriksaan Laboratorium pada Medical Check Up Perusahaan
Medical Check Up (MCU) atau pemeriksaan kesehatan merupakan salah satu layanan rumah sakit yang diberikan kepada pelanggannya baik itu pribadi maupun perusahaan. Pelayanan MCU di rumah sakit tempat saya bekerja sebagian besar berasal dari perusahaan, karena Kementerian Tenaga Kerja dan Transmigrasi memang mengharuskan tiap perusahaan melakukan MCU untuk karyawannya setiap